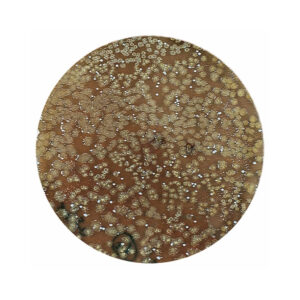

DISPONIBLE EN 4 FORMATOS:
- 120 ml.
- 250 ml.
- 500 ml.
- 1000 ml
Acondicionador Biológico Premium que restaura la calidad natural del agua reproduciendo un entorno saludable en su acuario. Es ideal para acuarios de agua dulce y salada, acuarios con plantas acuáticas, arrecife y estanques.
- Bacterias simbióticas vivas y robustas resistentes a los cambios físico-químicos.
- Aplicación directa al acuario, no requiere activación ni refrigeración para conservar sus propiedades.
- Producto más concentrado, con el tiempo aumenta su capacidad y acción metabólica
CARACTERISTICAS:
- Ultra Bioguard es un acondicionador Biológico Premium que restaura la calidad natural del agua reproduciendo un entorno saludable en su acuario.
- Es ideal para acuarios de agua dulce y salada, acuarios con plantas acuáticas, arrecife y estanques.
- Contiene una alta concentración de probióticos naturales aeróbicos y anaeróbicos, que pueden descomponer rápidamente el ácido nitroso, el amoniaco, los nitratos, el sulfuro de hidrógeno y otras sustancias nocivas.
- Utiliza una tecnología patentada que permite la conservación a largo plazo de diversas cepas microbianas para mantener su actividad y eficacia óptima.
- Contiene cepas de Bacillus y Lactobacillus para la descomposición del amoniaco, los nitritos y también los nitratos.
- Su acción biológica ayuda a mantener en buenas condiciones el sustrato de su acuario y los materiales filtrantes, pudiéndose añadir directamente sobre estas superficies para aumentar su efecto sinérgico.
- A diferencia del resto de acondicionadores biológicos, AZOO Ultra Bioguard no emite malos olores. De hecho, este producto ayuda a evitar los posibles malos olores en su acuario.
- Este acondicionador es un excelente alimento para los ejemplares juveniles de gambitas y peces.
- Altamente concentrado: Su fórmula está optimizada para lograr una alta concentración y un excelente rendimiento; 1ml de producto trata 10 litros de agua de su acuario.

COMPONENTES PRINCIPALES:
Contiene cepas de Bacillus y Lactobacillus
MODO DE EMPLEO:
- Uso regular y cambio de agua: Añadir 10 ml de Ultra Bioguard por cada 10 litros de agua del acuario cada 5-7 días. Para mejorar la calidad del agua cuando los peces están enfermos, añadir 10 ml por cada 100 litros de agua del acuario diariamente.
- Instalación de un filtro biológico en un acuario nuevo: Aplicar una dosis inicial de 30 ml por cada 100 litros de agua del acuario. Luego aplicar 1 dosis de 10 ml por cada 100 litros de agua del acuario en días alternos hasta alcanzar 10 dosis de la misma proporción. En condiciones normales, después de este período de 21 días, se habrá establecido un lecho bacteriano en su filtro biológico, estabilizando los niveles de amoniaco y nitrito a niveles seguros. Una vez finalizada esta etapa, puede comenzar con la dosis de uso normal: (10 ml/100L cada 5-7 días).
- Monitoreo de parámetros del agua: Puede monitorear la concentración de nitrito y nitrato, así como otros parámetros de interés, utilizando los medidores de calidad de agua AZOO
- Para garantizar una dispersión adecuada, agregue los aditivos en un área del acuario con suficiente flujo.
- Para los cambios de agua, puedes añadir aditivos al agua antes de verterla en el acuario. Evita mezclar distintos aditivos antes de añadirlos.
- Algunos productos para acuarios pueden reaccionar químicamente con otros; evite combinar varios productos simultáneamente para evitar precipitaciones o reacciones no deseadas.
- El tapón del frasco te ayudará a medir la dosis con precisión:
- La cavidad interior tiene capacidad para 5 ml.
- El volumen entre la cavidad interior y exterior contiene 10 ml.
- Ambas cavidades rellenas contienen un total de 15 ml.
- Un tapón completamente lleno contiene 20 ml.

RECOMENDACIONES Y ADVERTENCIAS:
- No apto para consumo humano.
- No ingerir. En caso de contacto con los ojos, enjuagar con abundante agua limpia y buscar atención médica.
- Mantener el producto fuera del alcance de los niños y mascotas.
- Agite el frasco antes de usar.
- Cerrar bien el botella después de cada uso.
- Conservar el frasco en un lugar fresco y seco, evitando la exposición directa al sol.
- Para uso exclusivo en acuarios con peces ornamentales.
DESCRIPCION DETALLADA:
Ultra Bioguard es un acondicionador biológico premium que restaura la calidad natural del agua replicando un ambiente saludable en su acuario.
Ultra Bioguard es ideal para acuarios de agua dulce y salada, acuarios con plantas acuáticas, arrecifes y estanques. Contiene una alta concentración de probióticos aeróbicos y anaeróbicos naturales, que pueden descomponer rápidamente el ácido nitroso, el amoníaco, los nitratos, el sulfuro de hidrógeno y otras sustancias nocivas.
Utiliza tecnología patentada que permite la conservación a largo plazo de diversas cepas microbianas para mantener su actividad y eficacia óptima. Contiene cepas de Bacillus y Lactobacillus para la descomposición de amoniaco, nitritos y nitratos.
Nuestras bacterias pueden descomponer rápidamente ácido nitroso, amoniaco, nitratos, sulfuro de hidrógeno y otras sustancias nocivas. Pueden purificar aún más el fondo del acuario y filtrar materia orgánica, desechos biológicos, alimentos no consumidos y otras sustancias.
Tres años de investigación y desarrollo para obtener un potente acondicionador biológico universal con diversas cepas de bacterias vivas que no emiten olores desagradables.
Bacterias reales de alta calidad que son mucho más robustas, concentradas y su fragancia aumenta con el tiempo.
Aprovechamos la simbiosis bacteriana para lograr un mayor rendimiento y conservación. Nuestra tecnología patentada permite la conservación a largo plazo de múltiples cepas microbianas, manteniendo una actividad y eficacia óptimas y en constante aumento. De esta forma, las cepas continúan desarrollándose durante el almacenamiento en el contenedor, adquiriendo un tono cada vez más oscuro en la solución y mejorando aún más su rendimiento.
Puede aplicar la solución directamente y secarla sobre el medio filtrante, el sustrato o la grava de su acuario.
Las cepas bacterianas de Ultra Bioguard tienen una alta tolerancia y robustez, siendo altamente activas en todo tipo de ambientes. Puede aplicar la solución directamente sobre sustratos y medios filtrantes mientras están secos, y las cepas se adherirán a ellos, activándose al sumergirlos en agua.
Alimento natural para camarones y peces juveniles.
Contiene abundantes probióticos con un diámetro celular de hasta 10 μm. Este producto puede utilizarse directamente para alimentar a juveniles de camarones y peces, o también puede añadirse a la dieta de peces y otros organismos ornamentales. Sus bacterias y probióticos se integran rápidamente en su microbiota intestinal como especies dominantes, aportando grandes beneficios a los habitantes del acuario, mejorando la digestión, el sistema inmunológico y aumentando su tasa de supervivencia.

Reviews
There are no reviews yet.